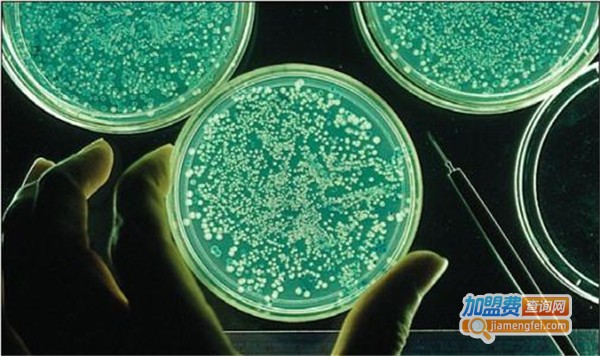

中科紫鑫基因加盟投资费用
中科紫鑫基因投资费用在12-32万元。

如今基因检测行业发展前景越来越好了,作为该行业中非常知名的品牌中科紫鑫基因,一定是有许多的人想要加盟的,那么加盟中科紫鑫基因需要多少钱?如何加盟?这些你都知道吗?如果不是特别的了解,可以点击右侧“
我要加盟”您将能够获得你所想要的资料哟!
中科紫鑫基因加盟条件:
1、认同中科紫鑫基因品牌,具有合法有效证件的自然人或者法人证件。
2、认同中科紫鑫基因品牌经营理念,有认真的事业态度,有志于共同发展中科紫鑫基因事业。
3、符合投资加盟需求的相应资金实力。
4、所开店铺须在指定经营区域内;店址需在繁华的商业街道或大型商场。
5、接受总部无条件的各项业务培训。
6、具被良好的商业信誉以及沟通领导的能力。
7、具有较强的进取精神,对企业管理具有基本概念。
 中科紫鑫基因加盟流程:
1、了解详情
中科紫鑫基因加盟流程:
1、了解详情
留下您的联系方式,便可获取第一手的加盟资料。如果您想深入了解加盟详情可以与网站上专业咨询师进行在线沟通。
2、实地考察
加盟商如果对电话咨询有所疑问可以前往加盟总部进行考察。
3、加盟申请
以书面形式或者邮件形式填写加盟申请表提交至总部,信息必须要保证真实有效。
4、签订合同
公司对于加盟商提交的申请书进行考核,符合申请条件,便可以签订加盟合同,协商其他的加盟事宜。
5、选址建店
总部会协助加盟商进行商圈调查,寻找合适的店铺。
6、设计装潢
中科紫鑫基因总部按照统一的设计方案,对加盟店进行设计,加盟商进行装潢。
7、人员培训
派遣相应人员前往总部进行系统化的培训。
8、开业准备
加盟商开业前工作会制定一系列的宣传策略,派专业的工作人员对其进行全面的撒网式的宣传,提高其在该区域的知名度,做好开业准备。
9、盛大开业
开业准备就绪后,加盟商可以选择良辰吉日开业,公司也会派工作人员前往指导。
中科紫鑫基因加盟优势:
1、品牌优势
中科紫鑫基因公司是国内该行业的领先公司,经过多年的经营与管理在业内形成了良好的口碑,有广大的客户群,稳定的员工输入途径,是国内知名的品牌公司。
2、产品优势
中科紫鑫基因细分市场、有效定位、精准作业,跟随中科紫鑫基因进入商机无限的市场蓝海。
3、技术优势
总部培训师分别为合作商提供理论培训、技术培训、手把手教技术。
4、培训优势
总部建立了一个专业的培训团队,将会为加盟商提供全方位的培训支持,包括老板培训、设计师培训、店长培训、导购培训、小区推广培训等,帮助加盟商提升销售团队和管理才能。
5、服务优势
永续服务项目、完整管理培训、周到店面经营管理辅导、统一的物源配送,为加盟者的经营保驾护航。
6、投资优势
中科紫鑫基因根据不同的投资能力和投资地域,设计出囊括了不同消费层次群体的需求经营模式。
 中科紫鑫基因加盟支持:
1、品牌形象支持
中科紫鑫基因加盟支持:
1、品牌形象支持
凡加盟中科紫鑫基因品牌的加盟商都能获得全套VIS视觉形象设计,以及logo的全权使用权用以品牌知名度引起消费者的关注。
2、整店输出支持
总部提供整店输出支持,包括开店选址、店内设计、装修风格、培训指导、产品陈列、运营管理等等方面的支持。
3、免费培训支持
开业前期,总部会邀请加盟商到总部培训一周左右,让加盟商了解产品的具体的使用产品,熟练掌握产品的操作流程以及销售手段。
4、物流配送支持
在产品供应及终端助销物料等店铺所需资源,公司配送服务能保证快捷、高效地实现供应流通,帮您及时满足市场需求。
5、媒体广告支持
总部充分利用企业资源,为客户进行360°广告媒体宣传。
6、市场运营支持
中科紫鑫基因总部有一套完整的销售积分系统,总部会将这一系统共享出来,让加盟店适用,实现积分销售,以此来提升消费者对中科紫鑫基因的销售依赖。同时,在销售方面,总部也会将一些优秀的经验分享给加盟商,以供借鉴和学习。
7、跟踪服务支持
公司将定期派专业营销人员为客户进行营销诊断,适时地调整营销策略,保证加盟店的良性运作。
8、选址装修支持
公司总部会协助加盟商进行当地市场分析,投资规划和店铺选址。
9、区域保护支持
加盟中科紫鑫基因是可以享受区域保护的,在一定的商圈范围内,只能有一家加盟店。不过,该商圈里的第一家加盟商可以向下发展加盟商或代理商,挣取加盟费或代理费及供货差价,增加加盟商的盈利方式。
10、话术支持
中科紫鑫基因总部会总结当下社会消费者的消费心理,将最能实现消费的话术教于商家,保证商家能够实现利润最大化。
更新于 2023-05-26